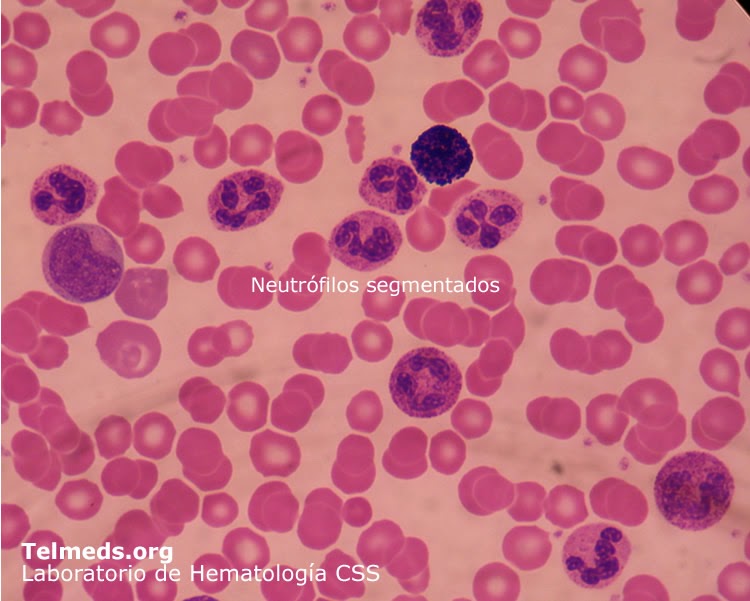
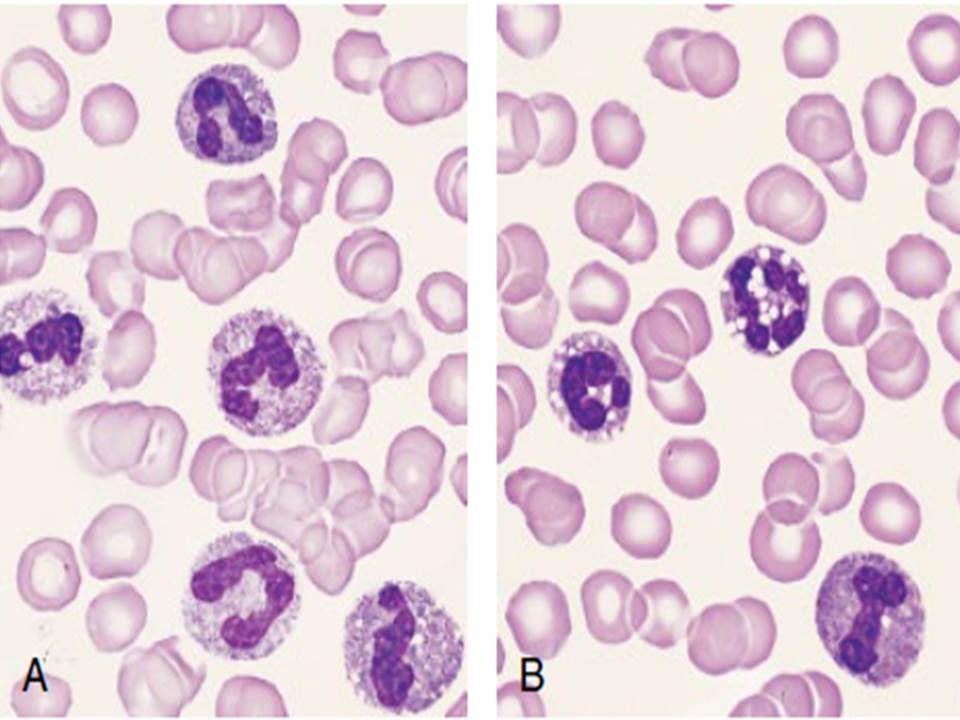

Para una adecuada interpretación del hemograma es necesario conocer de antemano las cifras de referencias en una población de sujetos sanos. Los laboratorios que tienen la capacidad para hacerlo, realizan en su zona geográfica, determinaciones en sujetos sanos de los rangos en que se mueven los distintos parámetros del hemograma. SERIE ROJA.. 125 de sangre o 14, 4 x 109/L, neutrófilos 0, 80 % y stab 0, 12 % y por último en estadio gangreno-so 17 570 leucocitos x mm3 o 17, 57 x109/L, neutrófilos 0, 83 % y stab 0, 13 %. Se señalaba entonces que no solo la leucocitosis

células sanguíneas de neutrófilos 965685 Foto de stock en Vecteezy

Neutrófilos Definición, función y valores en sangre

Inclusiones citoplasmáticas con aspecto de cuerpos de HowellJolly en los neutrófilos de un

Neutrófilos Definición, función y valores en sangre

Neutrófilo Hipersegmentado en 2022 Hematología, Histología, Medicos

Circulación De Neutrófilos En Los Vasos Sanguíneos Durante El Proceso De Infección Y Diapedesis

Segmented neutrophils Biological Science Picture Directory

Hipo y degranulación de neutrófilos segmentados

Repaso rápido sobre los Leucocitos + VIDEO Medicina mnemotecnias

Desviación a izquierda y signos inmunofenotípicos de displasia en serie... Download Scientific

Células importantes en hematología DESVIACION A LA IZQUIERDA

Neutrofilia y Leucemia Mieloide Crónica YouTube

fichero hematologia Desviación a la derecha
Hematologia Serie Leucocitaria, neutrofilos

Neutrófilo Hematología, Laboratorio médico, Hematíes

Neutrofilia. Qué hacer cuando tengo los neutrófilos altos YouTube

Alteraciones en neutrófilos en sangre periférica hematología Pinterest

Neutrofilos uDocz

El Desarrollo De Neutrófilos Infografía Ilustración Del Vector Ilustración del Vector
Atlas de trastornos hematológicos
Desviación leucocitaria. En hematología una desviación de la serie blanca, desviación en los leucocitos, desviación leucocitaria o desviación de la fórmula leucocitaria es un cambio en el recuento diferencial o fórmula leucocitaria, con cambios en las proporciones entre las diferentes etapas de desarrollo de los granulocitos.. Curiosidad médica, desviación a la izquierda. Archivo PDF: 431.89 Kb. En 1904, Arneth intentó determinar la edad relativa de los leucocitos neutrófilos circulantes en la sangre de acuerdo con la morfología de los núcleos. Este investigador mostró que los núcleos de los neutrófilos, a partir de la transformación de los mielocitos en la.